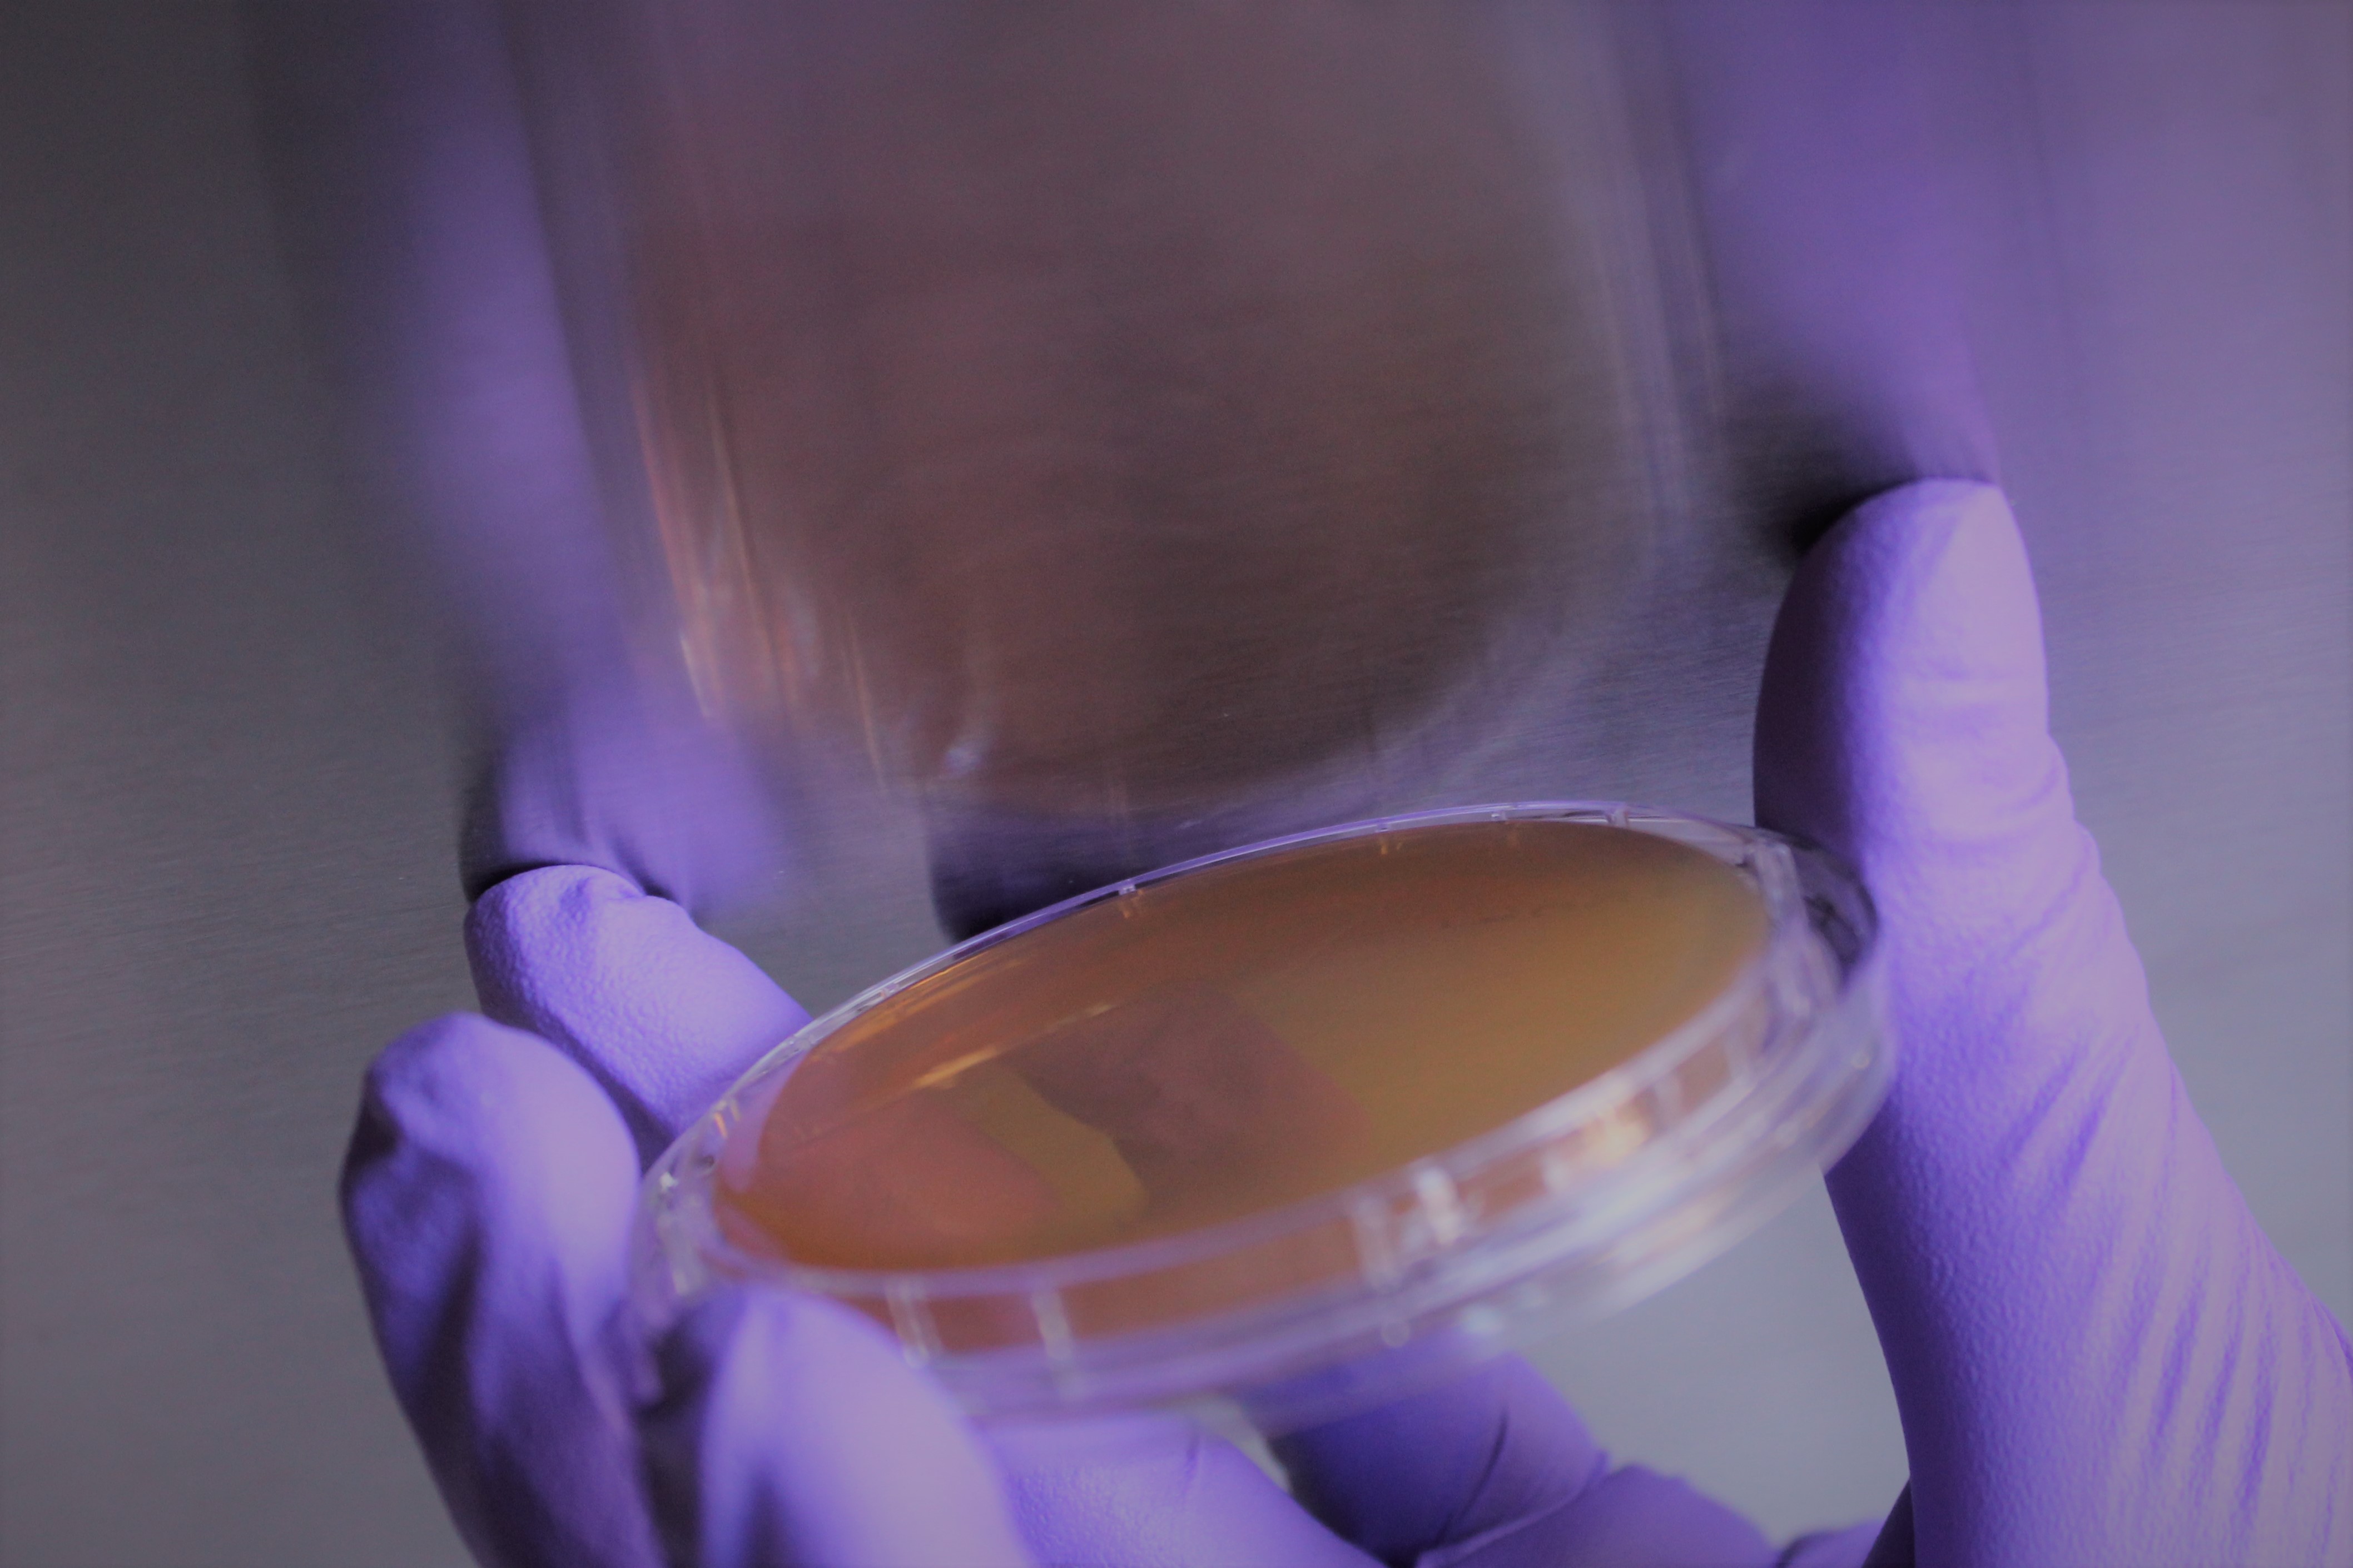
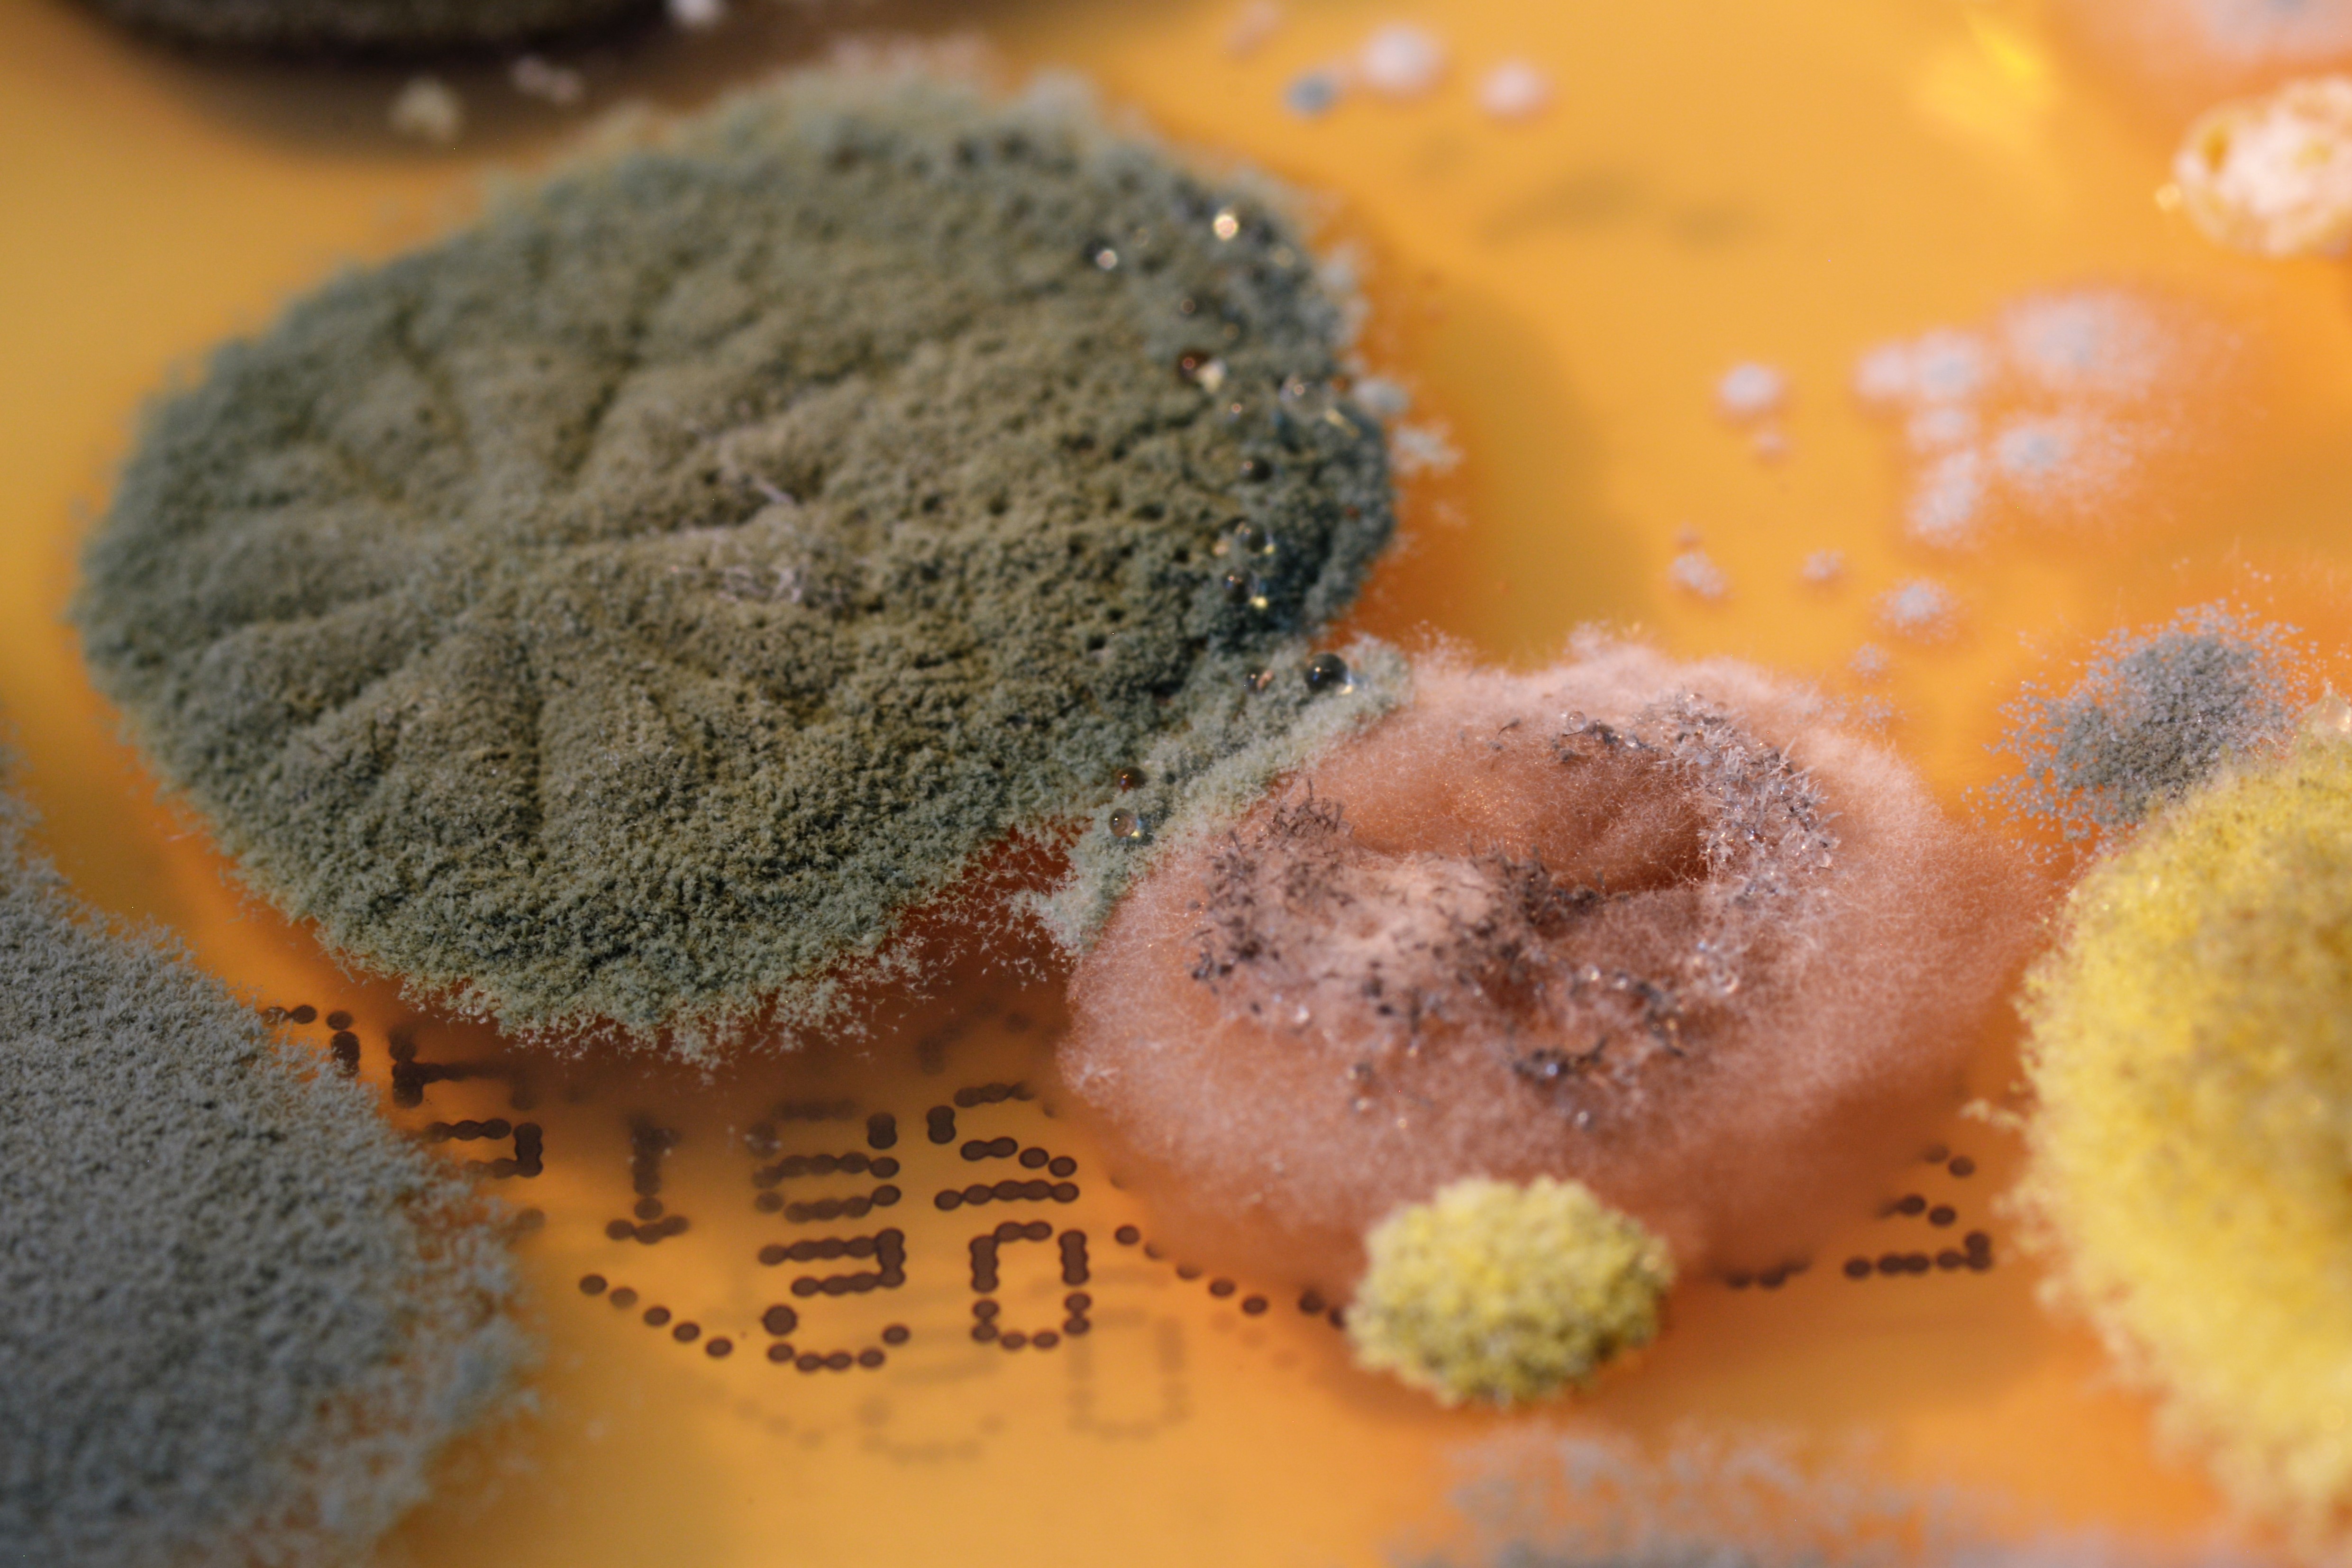

Biolytics Labor für biologische Analysen, Umweltschutz und -technik

Adresse
Straße:Karschhauser Str. 23 A
PLZ:40699
Ort:Erkrath, Hochdahl
Bundesland:Nordrhein-Westfalen
Land:Deutschland

BeschreibungBiolytiQs analysiert Ihre Proben gründlich, zuverlässig und schnell. Wir führen mikrobiologische und mykologische Analysen von Luft-, Material- und Kontaktproben sowie Wasser und Klimaanlagen (RLT) durch. Wir informieren Sie ausführlich und konkret über vorhandene biologische Schadstoffe – damit Sie sicher wissen, woran Sie sind, und mit geeigneten Abhilfemaßnahmen wieder ein gesundes Raumklima schaffen können.
KeywordsErkrath, Umweltschutz und -technik, Feuchtigkeit|Feuchtigkeitsschaden|Schimmel|Schimmelpilze|Ursachenanalyse
Links
facebook.com/BiolytiQs-GmbH-133049630728902/
ÖffnungszeitenMontag:08:00:00-16:00:00
Dienstag:08:00:00-16:00:00
Mittwoch:08:00:00-16:00:00
Donnerstag:08:00:00-16:00:00
Freitag:08:00:00-16:00:00
Samstag:-
Sonntag:-
Dienstag:08:00:00-16:00:00
Mittwoch:08:00:00-16:00:00
Donnerstag:08:00:00-16:00:00
Freitag:08:00:00-16:00:00
Samstag:-
Sonntag:-
Homepage

Information
Branche:
Umweltschutz und -technik
Aktualisiert:
Quelle:biolytiqs.de
Bewerten:
Daten aktualisieren
Löschantrag stellen